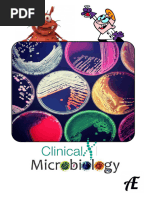

0% found this document useful (0 votes)
129 views20 pagesMicrobiology Lab Techniques Guide
This document provides an overview of bacterial identification and processing techniques. It discusses microscopy, including different types of microscopes and their parts. It also describes various specimen types that may be received for bacterial processing, including blood, CSF, throat/nasal swabs, and more. Staining techniques like Gram staining and acid-fast staining are explained, along with their significance in identifying bacteria. Finally, it touches on culture media and inoculation methods.
Uploaded by
TinCopyright
© © All Rights Reserved
We take content rights seriously. If you suspect this is your content, claim it here.
Available Formats
Download as PDF, TXT or read online on Scribd
0% found this document useful (0 votes)
129 views20 pagesMicrobiology Lab Techniques Guide
This document provides an overview of bacterial identification and processing techniques. It discusses microscopy, including different types of microscopes and their parts. It also describes various specimen types that may be received for bacterial processing, including blood, CSF, throat/nasal swabs, and more. Staining techniques like Gram staining and acid-fast staining are explained, along with their significance in identifying bacteria. Finally, it touches on culture media and inoculation methods.
Uploaded by
TinCopyright
© © All Rights Reserved
We take content rights seriously. If you suspect this is your content, claim it here.
Available Formats
Download as PDF, TXT or read online on Scribd
/ 20